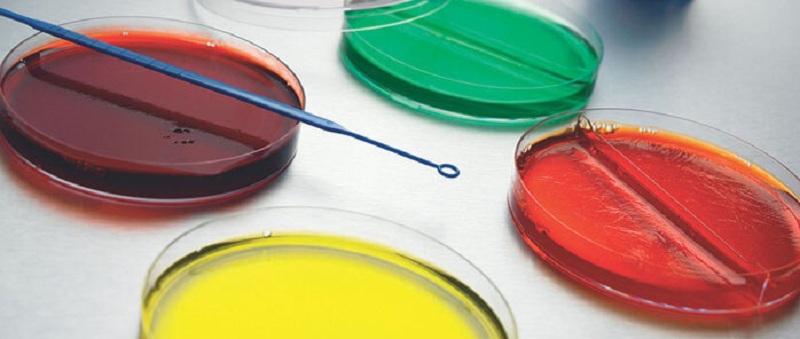
Dipotassium Phosphate được sử dụng để tạo đĩa thạch nuôi cấy vi khuẩn

21/06/2023
Mặc định
Lớn hơn
Dipotassium phosphate là một muối kali là muối kali của axit photphoric. Nó có vai trò như một bộ đệm. Nó là một muối kali và một photphat vô cơ.Dipotassium phosphate (K2HPO4) là một loại muối hòa tan trong nước cao, thường được sử dụng làm phân bón và phụ gia thực phẩm như một nguồn phốt pho và kali cũng như một chất đệm.
Kali photphat (K2HPO4) (cũng là kali hydro orthophotphat; kali photphat dibasic) là hợp chất vô cơ có công thức K2HPO4. (H2O) x (x = 0, 3, 6). Cùng với monokali photphat (KH2PO4. (H2O) x), nó thường được sử dụng làm phân bón, phụ gia thực phẩm và chất đệm. Nó là một chất rắn màu trắng hoặc không màu có thể hòa tan trong nước.
Tính chất hóa học của Dipotassium Phosphate - K2HPO4
Dipotassium Phosphate phản ứng với hydro clorua tạo thành axit photphoric và kali clorua. Phương trình hóa học được đưa ra dưới đây.
K2HPO4 + 2HCl → 2KCl + H3PO4
Dipotassium Phosphate phản ứng với một bazơ như natri hydroxit tạo thành dinatri hydro photphat và nước.
3K2HPO4 + 2NaOH → Na2HPO4 + 2K3PO4 + 2H2O

Công thức hóa học của Dipotassium phosphate
Với tình trạng thiếu hụt năng lượng, ô nhiễm môi trường ngày càng nghiêm trọng, Phương pháp sản xuất dipotassium hydrogen phosphate chủ yếu chứa chất trung hòa, muối của phương pháp trùn quế.
Trung hòa là kali hydroxit rắn được tạo thành dung dịch nước 30%, thêm từ từ dung dịch axit photphoric thích hợp (hàm lượng axit photpho là 50%), ở 90 ~ 100 ℃, thực hiện phản ứng trung hòa, chất chỉ thị (được thực hiện chỉ cho đến khi đỏ thấm với phenolphtalein, pH 8,5 ~ 9,0; được đun nóng đến 120 ~ 124 ℃ và cô đặc, sau đó loại bỏ bằng bộ lọc các chất không tan. Dịch lọc trong qua được làm lạnh để kết tinh dưới 20 ℃, sau đó qua ly tâm, làm khô, tạo thành thành phẩm là dipotassium hydro phosphate.
Quy trình quay trở lại; phương trình nguyên lý phản ứng của nó là: H3PO4+ 2KOH → K2HPO4+ 2H2O. Hoặc nó được sản xuất thương mại bằng cách trung hòa một phần axit photphoric với hai chất tương đương của kali clorua: H3PO4 + 2 KCl → K2HPO4 + 2 HCl.
Dipotassium phosphate cũng được sử dụng để tạo ra các dung dịch đệm và nó được sử dụng trong sản xuất agar đậu nành trypticase được sử dụng để tạo ra các đĩa thạch để nuôi cấy vi khuẩn.
Kali Phosphat, Dibasic là dạng dipotassium của axit photphoric, có thể được sử dụng như một chất bổ sung chất điện giải. Khi uống, kali photphat có thể ngăn chặn sự hấp thu của đồng vị phóng xạ photpho P 32 (P-32).
Dipotassium phosphate được sử dụng trong các loại sữa, đồ uống dạng bột khô, chất bổ sung khoáng chất. Nó được sử dụng trong các loại sữa không làm từ sữa để ngăn ngừa đông máu. Dipotassium phosphate cũng được sử dụng để làm dung dịch đệm và nó được sử dụng trong sản xuất thạch đậu nành trypticase được sử dụng để tạo đĩa thạch nuôi cấy vi khuẩn.
Dipotassium Phosphate được sử dụng để tạo đĩa thạch nuôi cấy vi khuẩn
Dipotassium Phosphate là một chất đệm và chất cô lập hiệu quả cho nhiều mục đích sử dụng, hoạt động như một chất cân bằng. DKP khi được sử dụng làm chất phụ gia hoặc chất bảo quản thực phẩm có hiệu quả cao trong việc ngăn ngừa đông tụ, và được sử dụng phổ biến trong thị trường kem không sữa như một chất đệm.
Ngoài ra, Dipotassium phosphate (K2HPO4) là một loại muối hòa tan trong nước cao, thường được sử dụng làm phân bón và phụ gia thực phẩm như một nguồn phốt pho và kali cũng như một chất đệm.
Dipotassium phosphate là một phụ gia thực phẩm, dipotosphat kali được sử dụng trong kem sữa giả, đồ uống bột khô, bổ sung khoáng chất, và nuôi cấy khởi đầu. Nó được sử dụng trong các loại kem không sữa để ngăn ngừa đông máu.
Trong đời sống, Dipotassium Phosphate - K2HPO4 chứa nhiều công dụng:
Nó hoạt động như một chất nhũ hóa, chất ổn định và chất tạo kết cấu; nó cũng là chất đệm, và tác nhân tạo chelat đặc biệt là đối với canxi trong các sản phẩm sữa ..
Dipotassium hydro phosphate có thể được sử dụng trong ngành công nghiệp thực phẩm, tác nhân kiềm nhẹ, thực phẩm nấm men của tác nhân lên men, gia vị, chất nuôi, sản phẩm sữa, v.v.; Cũng có thể được sử dụng làm môi trường nuôi cấy vi khuẩn, sản xuất nguyên liệu thô, phân bón lỏng của kali pyrophosphat, chất ức chế chất chống đông vón ethylene glycol, làm chất bổ sung dinh dưỡng cho thức ăn chăn nuôi vv;
Dipotassium phosphate được sử dụng trong phân bón, do đặc tính hòa tan trong nước cao nên nó thường được sử dụng vì nó cung cấp một lượng phốt pho cao cho cây đang phát triển.
Được sử dụng như một chất phụ gia thực phẩm, nhưng các cấp độ khác nhau cho thực phẩm và sử dụng phân bón.

Dipotassium Phosphate được sử dụng như một chất phụ gia thực phẩm
Được sử dụng để tăng độ pH của sữa sẽ làm tăng điện tích mạng micellar.
Được sử dụng như một sự thay thế cạnh tranh của canxi bằng natri trong các mixen.
Là một chất phụ gia thực phẩm, dipotassium phosphate được Cơ quan Quản lý Thực phẩm và Dược phẩm Hoa Kỳ phân loại là an toàn.
Hiện chưa có báo cáo về tác dụng phụ gây hại của Dipotassium Phosphate đối với làn da và sức khỏe người dùng khi sử dụng trong mỹ phẩm, các sản phẩm chăm sóc cá nhân. Nó được xếp mức 1 trên thang điểm 10 của EWG (trong đó 1 là thấp nhất, 10 là cao nhất về mức độ nguy hại).
https://patents.google.com/patent/CN104003362A/en
https://twenty-gen.online/2020/01/01/dipotassium-phosphate-la-gi-co-tac-dung-gi-trong-my-pham
https://pubchem.ncbi.nlm.nih.gov/compound/Dipotassium-hydrogen-phosphate#section=Biological-Test-Results
https://www.cosmopro.co.uk/post/manage-your-blog-from-your-live-site